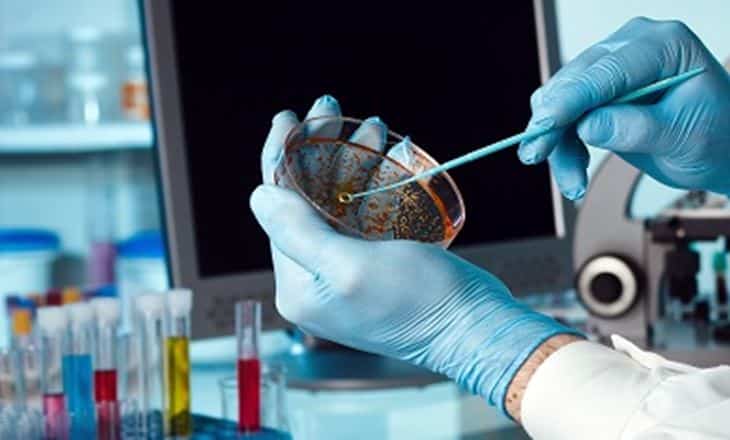

Se inició el período de inscripción para el curso de posgrado en Bioprocesos al que pueden participar los graduados, docentes y externos de la UTN.
Los docentes a cargo del posgrado son Marina de Escalada y José Luis Bolardi, y es de carácter presencial. Se desarrollará en el CETU -Sáenz Peña y Alberdi- de Cutral Co.
En total, serán 60 horas repartidas en 8 encuentros: el 28 y 29 de octubre; 4, 5; 11 y 12 y 25 y 26 de noviembre. Hasta el 20 de octubre hay tiempo para inscribirse. La certificación la realiza la facultar regional Buenos Aires de la UTN.
Los aranceles para docentes y graduados será de 4.500 pesos mientras que para los externos será de 5.000 pesos.
Las consultas e informes se pueden hacer a los siguientes correos electrónicos: elianavanesasalas@outlook.com y aabpojmaevich@gmail.com. Los teléfonos son 02994861767, de 9 a 12 y de 17:30 a 20. (Foto de archivo)